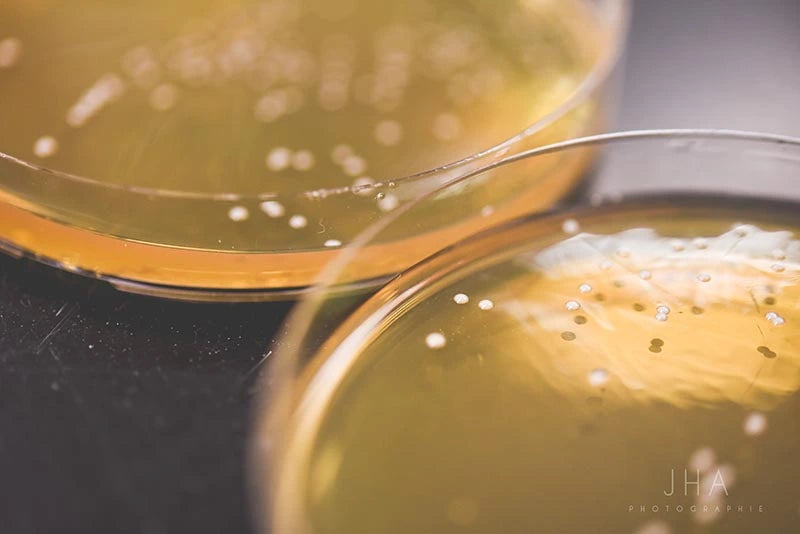

CONTRÔLES QUALITÉ ET CONSULTATIONS ABORDABLES POUR LES BRASSERIES
Posséder un laboratoire interne n'est pas une option réaliste pour la plupart des brasseries, bien que le contrôle de la qualité demeure essentiel.
Les services de laboratoire de Le Labo et d'Escarpment Labs vous offrent des tests fiables, des consultations d'experts et l'accès à des analyses avancées, sans les coûts ni la complexité liés à la création de votre propre laboratoire.
Grâce à nos forfaits flexibles de contrôle qualité (CQ) ou à des tests ponctuels, vous bénéficiez de la tranquilité d'esprit à chaque brassin et de données concrètes sur lesquelles vous pouvez agir.
Pour tout savoir sur la soumission d’un échantillon de contrôle de qualité,
consultez notre base de connaissances.

REGROUPE VOS SERVICES DE CONTRÔLE QUALITÉ
Nos forfaits CQ sont conçus pour offrir aux brasseries un accès constant à l’expertise d’Escarpment et du Labo, à un coût prévisible. Chaque forfait inclut un nombre défini de tests et d’heures de consultation, ainsi que des services spécialisés comme l’identification génétiques et l’analyse des sucres du moût. Si vous n’utilisez pas tout au cours d’un mois donné, vos crédits peuvent être convertis en achats de levures liquides ou de nutriments — rien n’est perdu.
Les forfaits donnent également accès à des avantages supplémentaires comme la livraison gratuite, des évaluations sensorielles et même l’accès à des souches expérimentales. Que vous brassiez 500 hL ou 20 000 hL, il existe un forfait adapté à vos besoins.

TESTS PONCTUELS
Vous n’êtes pas prêt pour un forfait? Nos options de tests ponctuels vous permettent de choisir exactement ce dont vous avez besoin, au moment où vous en avez besoin. Qu’il s’agisse de mise en banque microbiologique, d’identification génétiques ou d’analyses avancées, vous obtenez les mêmes résultats d’experts que nos clients avec forfait.
Cette approche flexible est idéale pour les brasseries qui souhaitent effectuer des vérifications de qualité occasionnelles ou obtenir des informations ciblées sans engagement mensuel. Combinez les tests ponctuels avec vos processus actuels en brasserie, ou utilisez-les comme tremplin vers un forfait CQ lorsque vous serez prêt à bénéficier d’un soutien plus constant.
BOÎTES DE PÉTRI PRÉ-COULÉES
Ensemencez vos échantillons de bière pour détecter les contaminants sans avoir à investir dans un autoclave ou une hotte à flux laminaire.
Nous produisons et vendons des boîtes de Pétri pré-coulées pour votre laboratoire de brasserie.
FOIRE AUX QUESTIONS
Que se passe-t-il si je n’utilise pas tous les services inclus dans mon forfait?
Pas d’inquiétude!
Les services non utilisés sont automatiquement convertis en crédits que vous pouvez utiliser pour commander des levures liquides ou des nutriments pour levures.
Cela signifie qu’il n’y a pas de «use it or lose it» — vous tirez pleinement profit de chaque forfait.
Ai-je besoin de m'abonner à un forfait?
Pas du tout!
Nos forfaits sont offerts sur une base mensuelle, sans contrat à long terme.
Et si vous avez seulement besoin de quelques tests de temps à autre, nos services ponctuels peuvent être achetés individuellement — vous ne payez que pour ce que vous utilisez.
Quel type de brasseries utilise ce service?
Toutes sortes!
Des petites brasseries de 500 hL aux grandes opérations de plus de 20 000 hL, nous offrons des forfaits et des services adaptés à chaque taille et à chaque style de brasserie.
Peu importe votre envergure, nous pouvons vous offrir le soutien en contrôle de qualité dont vous avez besoin.
Pourquoi devrais-je confier mes tests de contrôle de qualité à Le Labo et Escarpment Labs?
Collaborer avec Le Labo et Escarpment Labs vous donne accès à l’expertise et aux connaissances de nos équipes, ce qui vous aide à garantir que vos bières répondent toujours à vos normes élevées.
Gérer votre propre laboratoire ou embaucher un technicien à temps plein peut coûter cher — nos forfaits et services ponctuels offrent le même soutien en contrôle qualité, sans les frais généraux, afin de combler vos besoins en assurance qualité et de maintenir votre brasserie efficace.


